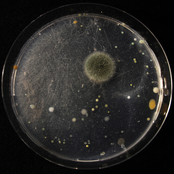
Human Baby

Loading details…
Artist
Phobophobes
12+ albums
post-brexit new wavepost-punkCrank waveindie rockart punk
about
Phobophobes congealed in the swamps of Brixton. Infectious fuzz drenched, head swirling organs n strings n things. User-contributed text is available under the Creative Commons By-SA License; additional terms may apply.